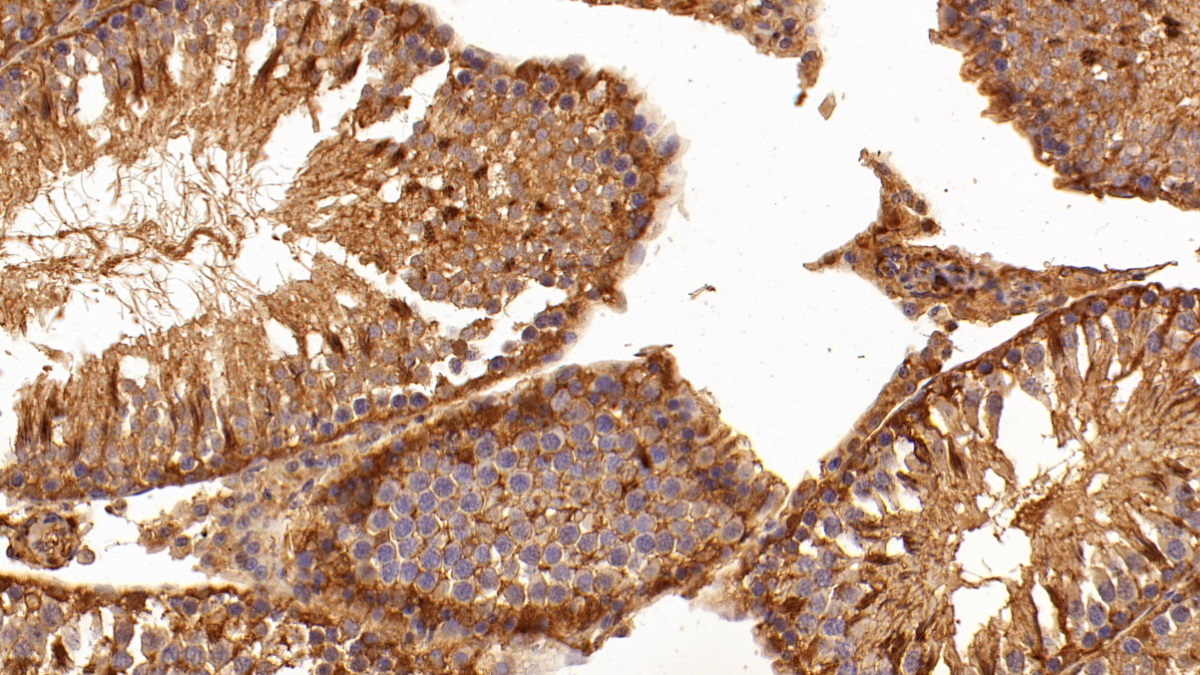

- KO-Validated
Polyclonal Antibody to Galectin 1 (GAL1)
LGALS1; GBP; HLBP14; Galaptin; Lectin,Galactoside-Binding Soluble 1; 14 kDa laminin-binding protein; Lactose-binding lectin 1; Putative MAPK-activating protein PM12; S-Lac lectin
- Product No.PAA321Hu01
- Organism SpeciesHomo sapiens (Human) Same name, Different species.
- SourcePolyclonal antibody preparation
- HostRabbit
- Potencyn/a
- Ig Type IgG
- PurificationAntigen-specific affinity chromatography followed by Protein A affinity chromatography
- LabelNone
- Immunogen RPA321Hu01-Recombinant Galectin 1 (GAL1)
- Buffer Formulation0.01M PBS, pH7.4, containing 0.05% Proclin-300, 50% glycerol.
- TraitsLiquid
- Concentration0.5mg/ml
- Organism Species MoreMus musculus (Mouse), Rattus norvegicus (Rat), Sus scrofa; Porcine (Pig)
- ApplicationsWB; IHC; ICC/IF; FCM
If the antibody is used in flow cytometry, please check FCM antibodies. - DownloadInstruction Manual
- UOM 20µl100µl 200µl 1ml 10ml
- FOB
US$ 95
US$ 221
US$ 316
US$ 790
US$ 3160
For more details, please contact local distributors!
SPECIFITY
The antibody is a rabbit polyclonal antibody raised against GAL1. It has been selected for its ability to recognize GAL1 in immunohistochemical staining and western blotting.
USAGE
Western blotting: 0.01-2μg/mL;
Immunohistochemistry: 5-20μg/mL;
Flow cytometry:20μg/ml;
Optimal working dilutions must be determined by end user.
STORAGE
Store at 4°C for frequent use. Stored at -20°C in a manual defrost freezer for two year without detectable loss of activity. Avoid repeated freeze-thaw cycles.
STABILITY
The thermal stability is described by the loss rate. The loss rate was determined by accelerated thermal degradation test, that is, incubate the protein at 37°C for 48h, and no obvious degradation and precipitation were observed. The loss rate is less than 5% within the expiration date under appropriate storage condition.
GIVEAWAYS
INCREMENT SERVICES
-
 Antibody Labeling Customized Service
Antibody Labeling Customized Service
-
 Protein A/G Purification Column
Protein A/G Purification Column
-
 Staining Solution for Cells and Tissue
Staining Solution for Cells and Tissue
-
 Positive Control for Antibody
Positive Control for Antibody
-
 Tissue/Sections Customized Service
Tissue/Sections Customized Service
-
 Phosphorylated Antibody Customized Service
Phosphorylated Antibody Customized Service
-
 Western Blot (WB) Experiment Service
Western Blot (WB) Experiment Service
-
 Immunohistochemistry (IHC) Experiment Service
Immunohistochemistry (IHC) Experiment Service
-
 Immunocytochemistry (ICC) Experiment Service
Immunocytochemistry (ICC) Experiment Service
-
 Flow Cytometry (FCM) Experiment Service
Flow Cytometry (FCM) Experiment Service
-
 Immunoprecipitation (IP) Experiment Service
Immunoprecipitation (IP) Experiment Service
-
 Immunofluorescence (IF) Experiment Service
Immunofluorescence (IF) Experiment Service
-
 Buffer
Buffer
-
 DAB Chromogen Kit
DAB Chromogen Kit
-
 SABC Kit
SABC Kit
-
 Long-arm Biotin Labeling Kit
Long-arm Biotin Labeling Kit
-
 Real Time PCR Experimental Service
Real Time PCR Experimental Service
| Magazine | Citations |
| International Journal of Oncology | Galectin-1-mediated cell adhesion, invasion and cell death in human anaplastic large cell lymphoma: Regulatory roles of cell surface glycans Pubmed:24589677 |
| Clinica Chimica Acta | Galectin-1 and galectin-3: plausible tumour markers for oral squamous cell carcinoma and suitable targets for screening high-risk population Pubmed:25578395 |
| Journal of Perinatal Medicine | Cord blood galectin-1 and-3 concentrations in term pregnancies with normal restricted and increased fetal growth PubMed: 24717333 |
| Biomaterials | Noninvasive small-animal imaging of galectin-1 upregulation for predicting tumor resistance to radiotherapy Pubmed:29272764 |
| Advances in Experimental Medicine and Biology | Molecules of Damage-Associated Patterns in Bronchoalveolar Lavage Fluid and Serum in Chronic Obstructive Pulmonary Disease Pubmed:29429028 |
| RESPIRATORY PHYSIOLOGY & NEUROBIOLOGY | Elevated level of Galectin-1 in bronchoalveolar lavage of patients with idiopathic pulmonary fibrosis Pubmed: 31678459 |
| Eur J Nucl Med Mol Imaging | Galectin expression detected by 68Ga-galectracer PET as a predictive biomarker of radiotherapy resistance Pubmed:35106644 |
| Medicine | Regulatory T cells, damage-associated molecular patterns, and myeloid-derived suppressor cells in bronchoalveolar lavage fluid interlinked with chronic obstructive … Pubmed:35687771 |
| In Vitro Bovine Embryo Production Using Medium's Supplemented with Recombinant Human Galectin-1 Buffered |
| Catalog No. | Related products for research use of Homo sapiens (Human) Organism species | Applications (RESEARCH USE ONLY!) |
| APA321Hu01 | Active Galectin 1 (GAL1) | Cell culture; Activity Assays. |
| EPA321Hu61 | Eukaryotic Galectin 1 (GAL1) | Positive Control; Immunogen; SDS-PAGE; WB. |
| RPA321Hu01 | Recombinant Galectin 1 (GAL1) | Positive Control; Immunogen; SDS-PAGE; WB. |
| PAA321Hu01 | Polyclonal Antibody to Galectin 1 (GAL1) | WB; IHC; ICC/IF; FCM |
| FAA321Hu01 | Anti-Galectin 1 (GAL1) Polyclonal Antibody | FCM |
| LAA321Hu71 | Biotin-Linked Polyclonal Antibody to Galectin 1 (GAL1) | WB |
| LAA321Hu81 | FITC-Linked Polyclonal Antibody to Galectin 1 (GAL1) | WB; IHC; ICC; IF. |
| MAA321Hu22 | Monoclonal Antibody to Galectin 1 (GAL1) | IHC |
| MAA321Hu21 | Monoclonal Antibody to Galectin 1 (GAL1) | WB |
| MEA321Hu | Mini Samples ELISA Kit for Galectin 1 (GAL1) | Enzyme-linked immunosorbent assay for Antigen Detection. |
| SEA321Hu | ELISA Kit for Galectin 1 (GAL1) | Enzyme-linked immunosorbent assay for Antigen Detection. |
| SCA321Hu | CLIA Kit for Galectin 1 (GAL1) | Chemiluminescent immunoassay for Antigen Detection. |
| LMA321Hu | Multiplex Assay Kit for Galectin 1 (GAL1) ,etc. by FLIA (Flow Luminescence Immunoassay) | FLIA Kit for Antigen Detection. |
| KSA321Hu01 | ELISA Kit DIY Materials for Galectin 1 (GAL1) | Main materials for "Do It (ELISA Kit) Yourself". |